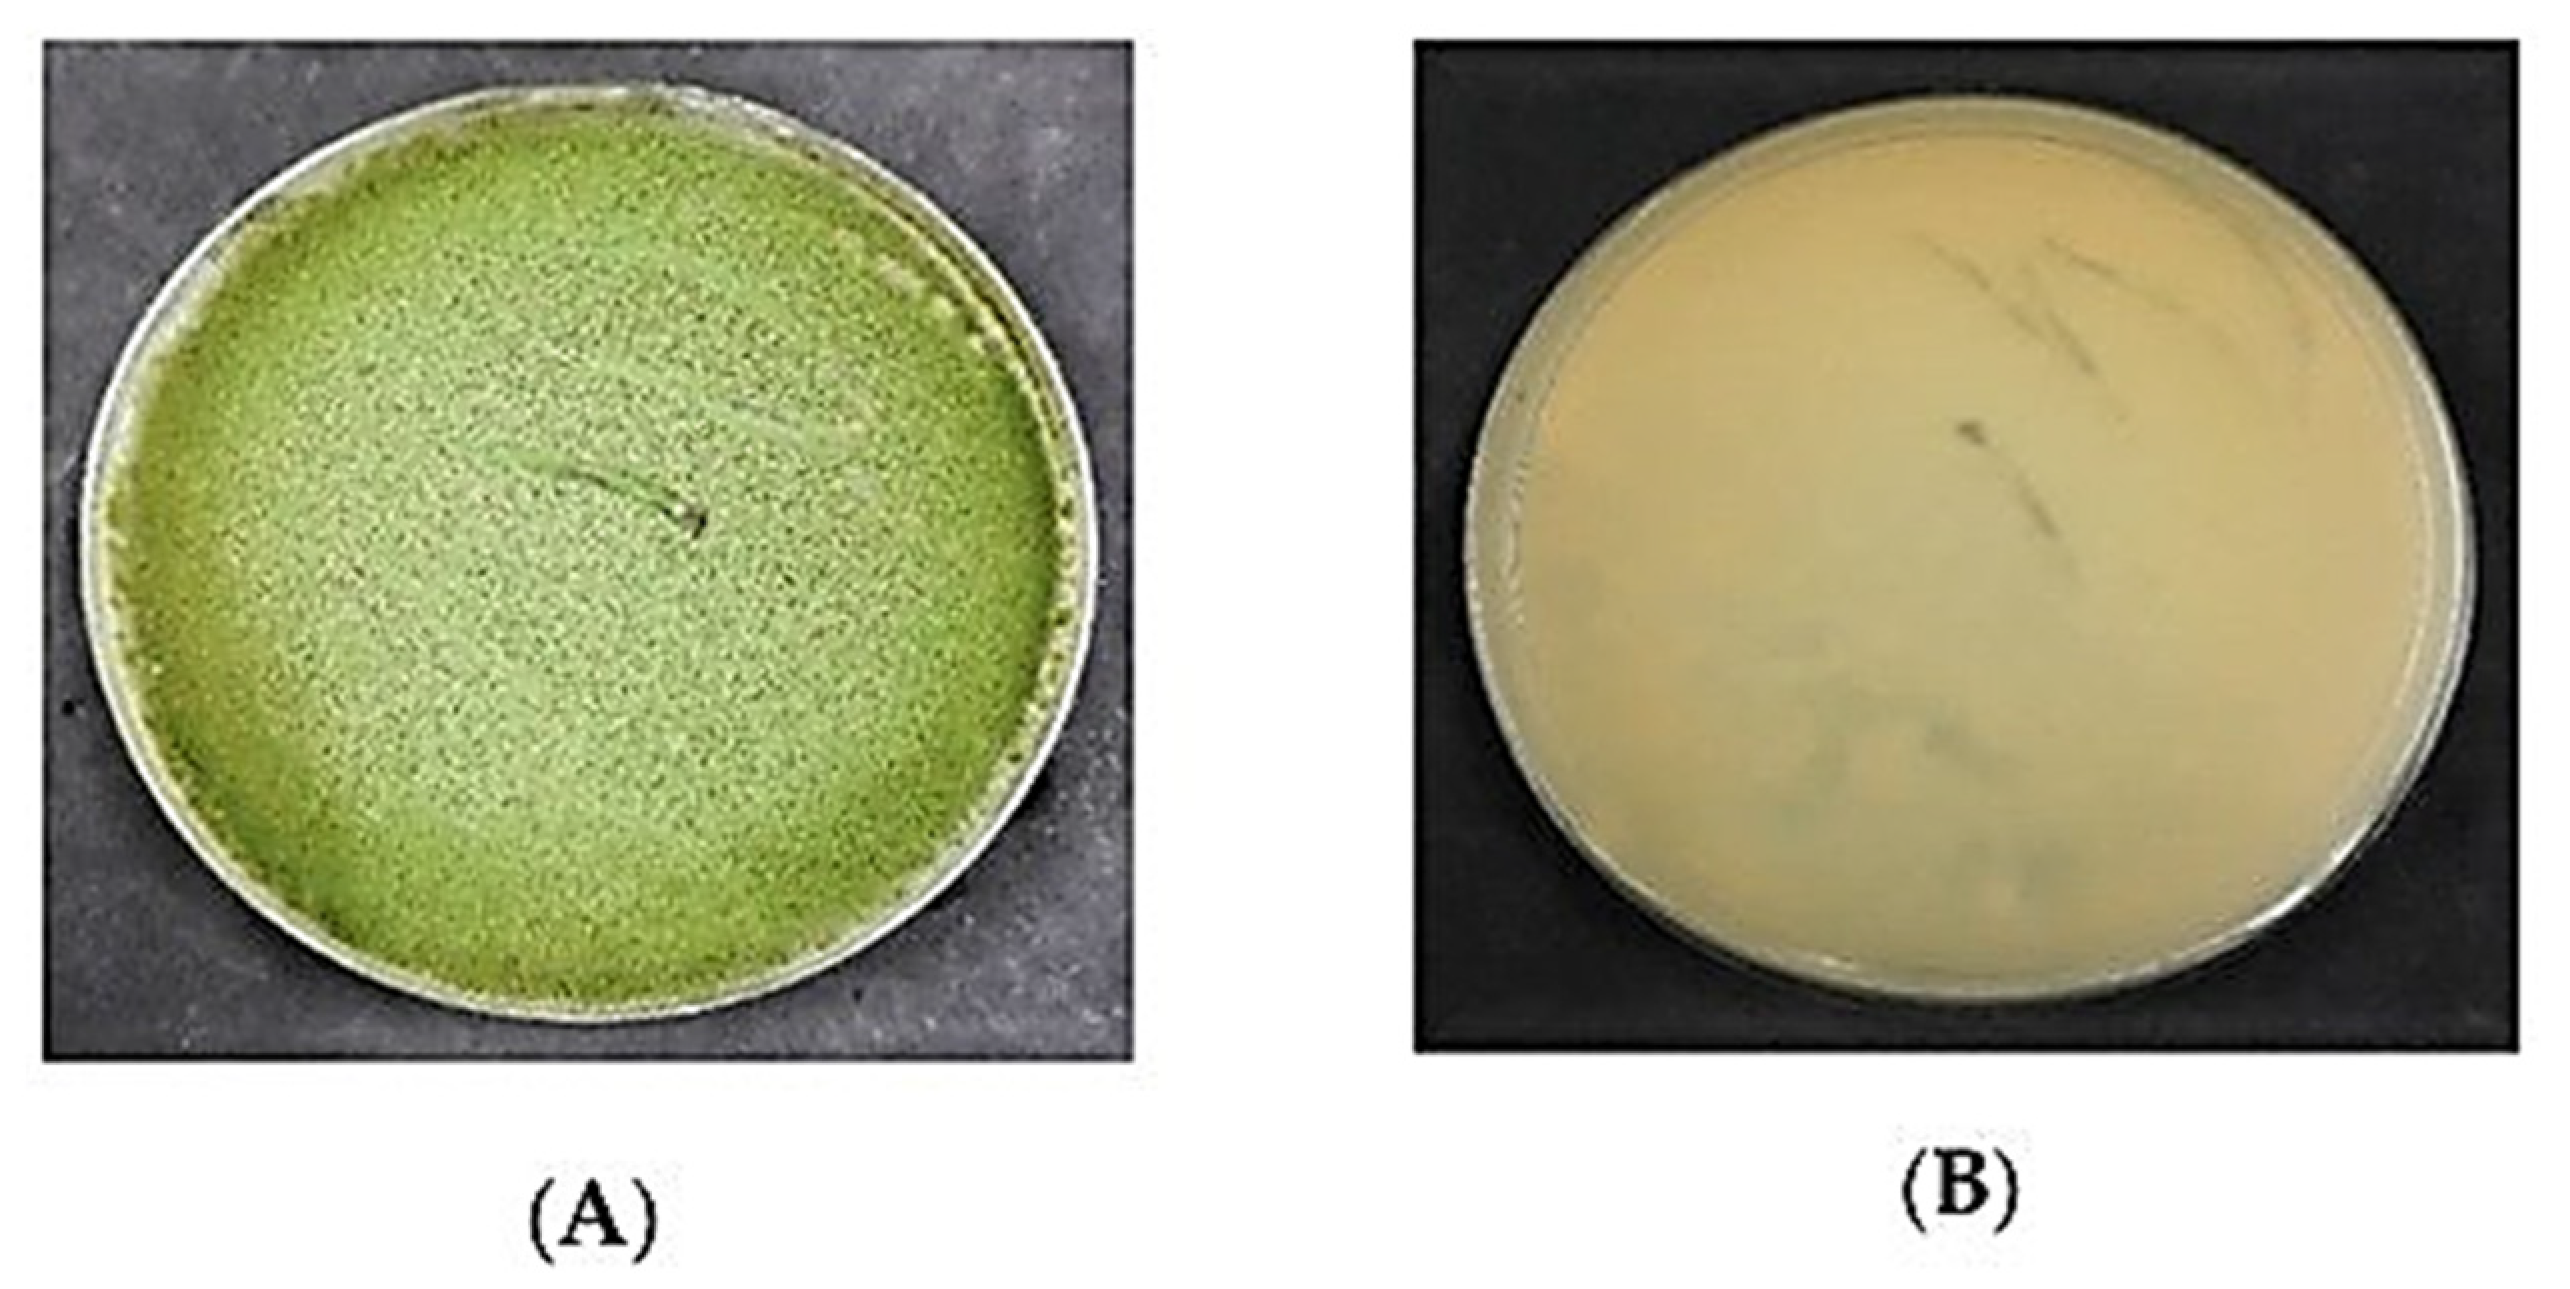
Separations 08 00098 g003 550

Chromatographic Analysis of Aflatoxigenic Aspergillus flavus Isolated from Malaysian Sweet Corn
Abstract
:1. Introduction
2. Materials and Methods
2.1. Chemicals and Reagents
2.2. Aflatoxin Standards Preparation
2.3. Strains of Aspergillus Flavus
2.4. Inoculation of Aspergillus Flavus
2.5. Extraction of Aflatoxins
2.6. High-Performance Liquid Chromatography Procedure
2.7. Validation of HPLC
2.8. Statistical Analysis
3. Results
3.1. Aspergillus Flavus on PDA
3.2. LOD and LOQ for Aflatoxin
3.3. Linearity
3.4. Recovery of Aflatoxins
3.5. Quantification of AFB1 and AFB2
4. Discussion
5. Conclusions
Author Contributions
Funding
Institutional Review Board Statement
Informed Consent Statement
Acknowledgments
Conflicts of Interest
References
- Medina, A.; Schmidt-Heydt, M.; Rodriguez, A.; Parra, R.; Geisen, R.; Magan, N. Impacts of environmental stress on growth, secondary metabolite biosynthetic gene clusters and metabolite production of xerotolerant/xerophilic fungi. Curr. Genet. 2015, 61, 325–334. [Google Scholar] [CrossRef] [PubMed]
- Abbas, H.K.; Accinelli, C.; Shier, W.T. Biological control of aflatoxin contamination in US crops and the use of bioplastic formulations of Aspergillus flavus biocontrol strains to optimize application strategies. J. Agric. Food Chem. 2017, 65, 7081–7087. [Google Scholar] [CrossRef] [PubMed]
- Dias, C.; Aires, A.; Saavedra, M.J. Antimicrobial activity of isothiocyanates from cruciferous plants against methicillin-resistant Staphylococcus aureus (MRSA). Int. J. Mol. Sci. 2014, 15, 19552–19561. [Google Scholar] [CrossRef] [PubMed] [Green Version]
- Assunção, R.; Martins, C.; Viegas, S.; Viegas, C.; Jakobsen, L.S.; Pires, S.; Alvito, P. Climate change and the health impact of aflatoxins exposure in Portugal–an overview. Food Addit. Contam. Part A 2018, 35, 1610–1621. [Google Scholar] [CrossRef] [PubMed] [Green Version]
- Van der Fels-Klerx, H.; Vermeulen, L.; Gavai, A.; Liu, C. Climate change impacts aflatoxin B1 in maize aflatoxin M1 in milk: A case study of maize grown in Eastern Europe and imported to the Netherlands. PLoS ONE 2019, 14, e0218956. [Google Scholar] [CrossRef] [Green Version]
- Mohammed, A.; Chala, A.; Ojiewo, C.; Dejene, M.; Fininsa, C.; Ayalew, A.; Arias, R.S. Integrated management of Aspergillus species and aflatoxin production in groundnut (Arachis hypogaea L.) through the application of farmyard manure and seed treatments with fungicides and Trichoderma species. Afr. J. Plant Sci. 2018, 12, 196–207. [Google Scholar]
- Prakash, B.; Kedia, A.; Mishra, P.K.; Dubey, N. Plant essential oils as food preservatives to control molds, mycotoxin contamination, and oxidative deterioration of agri-food commodities–Potentials and challenges. Food Control 2015, 47, 381–391. [Google Scholar] [CrossRef]
- Fente, C.; Ordaz, J.J.; Vazquez, B.; Franco, C.; Cepeda, A. New additive for culture media for rapid identification of aflatoxin-producing Aspergillus strains. Appl. Environ. Microbiol. 2001, 67, 4858–4862. [Google Scholar] [CrossRef] [Green Version]
- Hruska, Z.; Yao, H.; Kincaid, R.; Brown, R.; Cleveland, T.; Bhatnagar, D. Fluorescence excitation-emission features of aflatoxin and related secondary metabolites and their application for rapid detection of mycotoxins. Food Bioprocess Technol. 2014, 7, 1195–1201. [Google Scholar] [CrossRef]
- Maragos, C.; Appell, M.; Lippolis, V.; Visconti, A.; Catucci, L.; Pascale, M. Use of cyclodextrins as modifiers of fluorescence in the detection of mycotoxins. Food Addit. Contam. 2008, 25, 164–171. [Google Scholar] [CrossRef]
- Chandra, H.; Bahuguna, J.; Singh, A. Detection of aflatoxin in Zea mays L. from Indian markets by competitive ELISA. Octa J. Biosci. 2013, 1, 62–68. [Google Scholar]
- Ostry, V.; Malir, F.; Toman, J.; Grosse, Y. Mycotoxins as human carcinogens—the IARC Monographs classification. Mycotoxin Res. 2017, 33, 65–73. [Google Scholar] [CrossRef]
- Hua, S.S.T.; Parfitt, D.E.; Sarreal, S.B.L.; Sidhu, G. Dual culture of atoxigenic and toxigenic strains of Aspergillus flavus to gain insight into repression of aflatoxin biosynthesis and fungal interaction. Mycotoxin Res. 2019, 35, 381–389. [Google Scholar] [CrossRef]
- Waliyar, F.; Osiru, M.; Ntare, B.; Kumar, K.; Sudini, H.; Traore, A.; Diarra, B. Post-harvest management of aflatoxin contamination in groundnut. World Mycotoxin J. 2015, 8, 245–252. [Google Scholar] [CrossRef]
- Xie, L.; Chen, M.; Ying, Y. Development of methods for determination of aflatoxins. Crit. Rev. Food Sci. Nutr. 2016, 56, 2642–2664. [Google Scholar] [CrossRef] [PubMed]
- Camiletti, B.X.; Torrico, A.K.; Maurino, M.F.; Cristos, D.; Magnoli, C.; Lucini, E.I.; Pecci, M.l.P.G. Fungal screening and aflatoxin production by Aspergillus section Flavi isolated from pre-harvest maize ears grown in two Argentine regions. Crop Prot. 2017, 92, 41–48. [Google Scholar] [CrossRef]
- Saldan, N.C.; Almeida, R.T.; Avíncola, A.; Porto, C.; Galuch, M.B.; Magon, T.F.; Oliveira, C.C. Development of an analytical method for identification of Aspergillus flavus based on chemical markers using HPLC-MS. Food Chem. 2018, 241, 113–121. [Google Scholar] [CrossRef] [PubMed]
- Abbas, H.K.; Zablotowicz, R.; Weaver, M.; Horn, B.; Xie, W.; Shier, W. Comparison of cultural and analytical methods for determination of aflatoxin production by Mississippi Delta Aspergillus isolates. Can. J. Microbiol. 2004, 50, 193–199. [Google Scholar] [CrossRef] [PubMed] [Green Version]
- Sadhasivam, S.; Britzi, M.; Zakin, V.; Kostyukovsky, M.; Trostanetsky, A.; Quinn, E.; Sionov, E. Rapid detection, and identification of mycotoxigenic fungi and mycotoxins in stored wheat grain. Toxins 2017, 9, 302. [Google Scholar] [CrossRef] [Green Version]
- Khan, R.; Ghazali, M.F.; Mahyudin, N.A.; Samsudin, N.I.P. Morphological characterization, and determination of aflatoxigenic and non-aflatoxigenic Aspergillus flavus isolated from sweet corn kernels and soil in Malaysia. Agriculture 2020, 10, 450. [Google Scholar] [CrossRef]
- AOAC. Official Methods of Analysis of AOAC International; AOAC International: Rockville, MD, USA, 2016; ISBN 978-0-935584-87-5. [Google Scholar]
- Paez, V.; Barrett, W.B.; Deng, X.; Diaz-Amigo, C.; Fiedler, K.; Fuerer, C.; Hostetler, G.L.; Johnson, P.; Joseph, G.; Konings, E.J.; et al. AOAC SMPR® 2016.002. J. AOAC Int. 2016, 99, 1122–1124. [Google Scholar] [CrossRef]
- Alshannaq, A.F.; Gibbons, J.G.; Lee, M.K.; Han, K.H.; Hong, S.B.; Yu, J.H. Controlling aflatoxin contamination and propagation of Aspergillus flavus by a soy-fermenting Aspergillus oryzae strain. Sci. Rep. 2018, 8, 16871. [Google Scholar] [CrossRef]
- Dorner, J.W.; Lamb, M.C. Development and commercial use of Afla-guard®, an aflatoxin biocontrol agent. Mycotoxin Res. 2006, 22, 33–38. [Google Scholar] [CrossRef] [PubMed]
- Khan, R.; Ghazali, F.M.; Mahyudin, N.A.; Samsudin, N.I.P. Co-Inoculation of aflatoxigenic and non-aflatoxigenic strains of Aspergillus flavus to assess the efficacy of non-aflatoxigenic strains in growth inhibition and aflatoxin B1 reduction. Agriculture 2021, 11, 198. [Google Scholar] [CrossRef]
- Lahouar, A.; Crespo-Sempere, A.; Marín, S.; Saïd, S.; Sanchis, V. Toxigenic molds in Tunisian and Egyptian sorghum for human consumption. J. Stored Prod. Res. 2015, 63, 57–62. [Google Scholar] [CrossRef] [Green Version]
- Rank, C.; Klejnstrup, M.L.; Petersen, L.M.; Kildgaard, S.; Frisvad, J.C.; Gotfredsen, H.C.; Larsen, O.T. Comparative chemistry of Aspergillus oryzae (RIB40) and A. flavus (NRRL 3357). Metabolites 2012, 2, 39–56. [Google Scholar] [CrossRef]
- Medina, A.; Mohale, S.; Samsudin, N.I.P.; Rodriguez-Sixtos, A.; Rodriguez, A.; Magan, N. Biocontrol of mycotoxins: Dynamics and mechanisms of action. Curr. Opin. Food Sci. 2017, 17, 41–48. [Google Scholar] [CrossRef]
- Khan, R.; Ghazali, F.M.; Mahyudin, N.A.; Samsudin, N.I.P. Biocontrol of aflatoxins using non-aflatoxigenic Aspergillus flavus: A literature review. J. Fungi 2021, 7, 381. [Google Scholar] [CrossRef]
- Dagnas, S.; Onno, B.; Membré, J.M. Modeling growth of three bakery product spoilage molds as a function of water activity, temperature, and pH. Int. J. Food Microbiol. 2014, 186, 95–104. [Google Scholar] [CrossRef]
- Probst, C.; Bandyopadhyay, R.; Cotty, P. Diversity of aflatoxin-producing fungi and their impact on food safety in sub-Saharan Africa. Int. J. Food Microbiol. 2014, 174, 113–122. [Google Scholar] [CrossRef] [PubMed]
- Bandyopadhyay, R.; Ortega-Beltran, A.; Akande, A.; Mutegi, C.; Atehnkeng, J.; Kaptoge, L.; Cotty, P. Biological control of aflatoxins in Africa: Current status and potential challenges in the face of climate change. World Mycotoxin J. 2016, 9, 771–789. [Google Scholar] [CrossRef] [Green Version]
- Sarma, U.P.; Bhetaria, P.J.; Devi, P.; Varma, A. Aflatoxins: Implications on health. Indian J. Clin. Biochem. 2017, 32, 124–133. [Google Scholar] [CrossRef] [PubMed]
- Mellon, J.E. Extracellular xylanolytic and pectinolytic hydrolase production by Aspergillus flavus isolates contributes to crop invasion. Toxins 2015, 7, 3257–3266. [Google Scholar] [CrossRef]
- Barrett, C.B.; Bevis, L.E. The self-reinforcing feedback between low soil fertility and chronic poverty. Nat. Geosci. 2015, 8, 907–912. [Google Scholar] [CrossRef]
- Ehrlich, K.; Moore, G.; Mellon, J.; Bhatnagar, D. Challenges facing the biological control strategy for eliminating aflatoxin contamination. World Mycotoxin J. 2015, 8, 225–233. [Google Scholar] [CrossRef]
- Rogers, H.A. How composition methods are developed and validated. J. Agric. Food Chem. 2013, 61, 8312–8316. [Google Scholar] [CrossRef]
- Currie, L.A. Detection and quantification limits: Origins and historical overview. Anal. Chim. Acta 1999, 391, 127–134. [Google Scholar] [CrossRef]
- Şengül, Ü. Comparing determination methods of detection and quantification limits for aflatoxin analysis in hazelnut. J. Food Drug Anal. 2016, 24, 56–62. [Google Scholar] [CrossRef] [Green Version]
- Trucksess, M.W.; Stack, M.E.; Nesheim, S.; Albert, R.H.; Romer, T.R. Multifunctional column coupled with liquid chromatography for determination of aflatoxins B1, B2, G1, and G2 in corn, almonds, Brazil nuts, peanuts, and pistachio nuts: Collaborative study. J. AOAC Int. 1994, 77, 1512–1521. [Google Scholar] [CrossRef]

| AF | LOD (ppb) a | LOQ (ppb) b | Calibration Curve c | R2 |
|---|---|---|---|---|
| AFB1 | 0.072 | 0.220 | y = 55,012, 9.1 + 16 | 0.9960 |
| AFB2 | 0.062 | 0.180 | y = 1.92317 +16 | 0.9952 |
| Spiked Levels (ppb) | Recovery of Aflatoxins (%) | |
|---|---|---|
| AFB1 (ppb) | AFB2 (ppb) | |
| 80 | 81.3 | 86.0 |
| 60 | 77.5 | 82.5 |
| 20 | 77.6 | 76.1 |
| 10 | 73.0 | 79.4 |
| Strain No. | Sclerotial Type | Concentrations | |
|---|---|---|---|
| AFB1 (ppb) | AFB2 (ppb) | ||
| AKR1 | - | - | - |
| AKR2 | L | 0.278 ± 0.12 | - |
| AKR3 | S | 0.221 ± 0.05 | - |
| AKR4 | S | 0.315 ± 0.11 | - |
| AKR5 | L | - | - |
| AKR6 | S | 0.636 ± 0.51 | - |
| AKR7 | S | 0.428 ± 1.04 | - |
| AKR8 | S | 2.290 ± 0.68 | 2.481 ± 1.04 |
| AKR9 | S | - | 2.113 ± 0.64 |
| AKR10 | L | 0.462 ± 0.39 | 0.548 ± 0.62 |
| AKR11 | L | 0.508 ± 0.26 | - |
| AKR12 | L | 0.609 ± 0.11 | - |
| ARV13 | L | 0.284 ± 0.09 | - |
| ARV14 | S | 0.423 ± 0.12 | - |
| ARV15 | - | 0.265 ± 0.59 | - |
| ARV16 | - | 0.488 ± 0.94 | 5.715 ± 0.94 |
| ARV17 | S | 3.848 ± 0.31 | 5.198 ± 0.05 |
| ARV18 | S | 1.550 ± 0.53 | 2.165 ± 0.35 |
| ARV19 | L | 0.309 ± 0.48 | - |
| ARV20 | L | 1.163 ± 0.16 | - |
| ARV21 | L | 3.538 ± 0.53 | 0.640 ± 0.01 |
| ARV22 | L | 2.512 ± 0.89 | - |
| AK23 | S | 1.575 ± 0.13 | 0.332 ± 0.29 |
| AK24 | L | - | - |
| AK25 | S | 0.659 ± 0.34 | 0.751 ± 0.35 |
| AK26 | S | - | 1.191 ± 0.39 |
| AK27 | S | - | 0.536 ± 0.39 |
| AK28 | S | - | 0.339 ± 0.26 |
| AK29 | S | - | 0.362 ± 0.21 |
| AK30 | S | - | 2.142 ± 0.11 |
| AKL31 | S | - | 1.213 ± 0.14 |
| AKL32 | S | 0.429 ± 0.02 | 0.330 ± 0.13 |
| AKL33 | S | 0.267 ± 0.21 | - |
| AKL34 | L | - | - |
| AKL35 | L | - | - |
| AKL36 | L | - | - |
| AKL37 | L | - | - |
| AKL38 | S | - | 8.665 ± 0.19 |
| AKL39 | L | - | - |
| AKL40 | S | 0.659 ± 0.12 | 4.928 ± 0.30 |
| NRRL 21,882 | - | - | - |
| NRRL 3357 | S | 1.142 ± 0.11 | 4.928 ± 0.12 |
Publisher’s Note: MDPI stays neutral with regard to jurisdictional claims in published maps and institutional affiliations. |
© 2021 by the authors. Licensee MDPI, Basel, Switzerland. This article is an open access article distributed under the terms and conditions of the Creative Commons Attribution (CC BY) license (https://creativecommons.org/licenses/by/4.0/).
Share and Cite
Khan, R.; Ghazali, F.M.; Mahyudin, N.A.; Samsudin, N.I.P. Chromatographic Analysis of Aflatoxigenic Aspergillus flavus Isolated from Malaysian Sweet Corn. Separations 2021, 8, 98. https://doi.org/10.3390/separations8070098
Khan R, Ghazali FM, Mahyudin NA, Samsudin NIP. Chromatographic Analysis of Aflatoxigenic Aspergillus flavus Isolated from Malaysian Sweet Corn. Separations. 2021; 8(7):98. https://doi.org/10.3390/separations8070098
Chicago/Turabian StyleKhan, Rahim, Farinazleen Mohamad Ghazali, Nor Ainy Mahyudin, and Nik Iskandar Putra Samsudin. 2021. "Chromatographic Analysis of Aflatoxigenic Aspergillus flavus Isolated from Malaysian Sweet Corn" Separations 8, no. 7: 98. https://doi.org/10.3390/separations8070098
APA StyleKhan, R., Ghazali, F. M., Mahyudin, N. A., & Samsudin, N. I. P. (2021). Chromatographic Analysis of Aflatoxigenic Aspergillus flavus Isolated from Malaysian Sweet Corn. Separations, 8(7), 98. https://doi.org/10.3390/separations8070098

